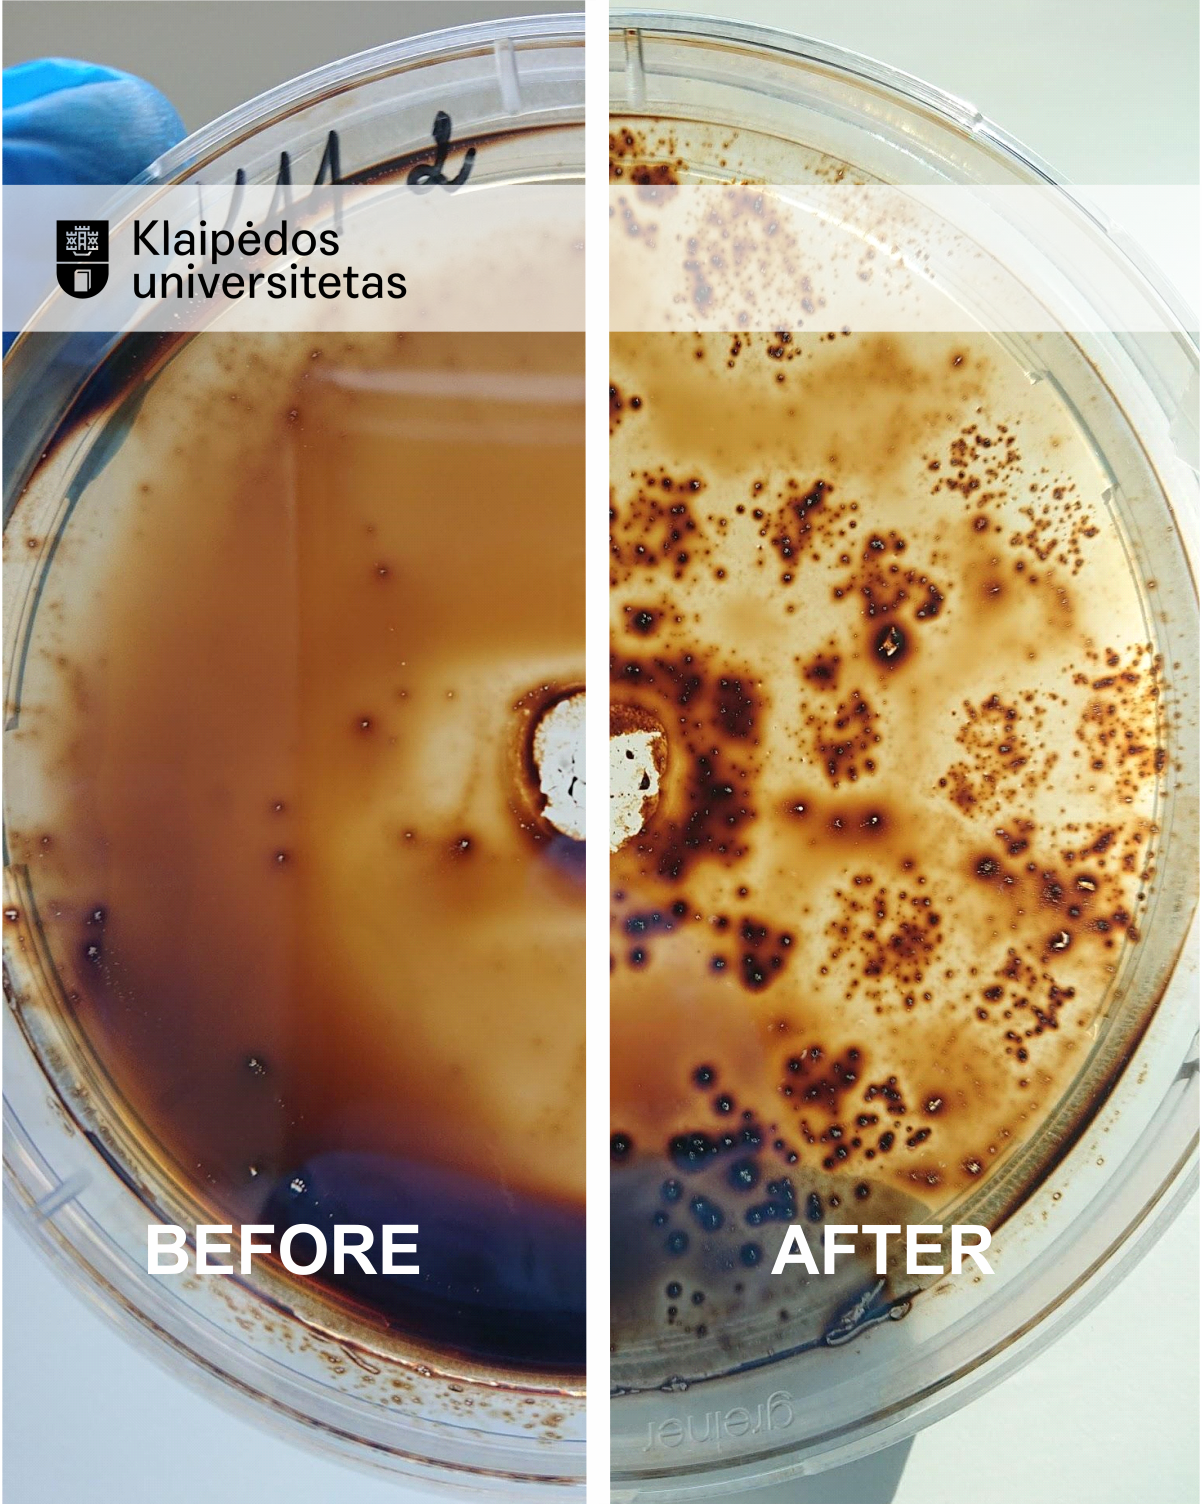

„Tikimės pasinaudoti stipraus klasterio ekspertų tinklu, rasti partnerių jau vystomų ir naujų inovatyvių produktų kūrimui. Savo darbais prisidėsime prie klasterio žinomumo didinimo, veiklų viešinimo Lietuvoje bei užsienyje. Mūsų kuriami produktai, tikiu, prisidės prie to, kad Lietuva taptų švariųjų technologijų lydere Baltijos jūros regione“,– sako startuolio „Inobiostar“ įkūrėja dr. Tatjana Paulauskienė.
Sparčiai plėtojamas KU startuolis „Inobiostar“ įkurtas 2020 metais. Įmonė teikia mokslinių tyrimų ir eksperimentinės plėtros paslaugas, padeda surasti ir įgyvendinti netradicinius sprendimus, vykdo sukurtų produktų komercinimą bei siūlo konsultavimo paslaugas.
Šiuo metu KU drauge su „Inobiostar“ vykdo Mokslo, inovacijų ir technologijos agentūros (MITA) finansuojamą projektą – „InoBioTech Baltija“, kurio tikslas sukurti biotechnologiją, leidžiančią neutralizuoti naftos išsiliejimų jūroje padarinius. Kuriama technologija jau yra apsaugota – gautas nacionalinis patentas bei pateikta prioritetinė paraiška ir jos kopija Europos patentų tarnybai. Kuriamos technologijos pagrindu pagamintą produktą bus siūloma licencijuoti. Išradimo autorės – Jūros tyrimų instituto vyresnioji mokslo darbuotoja Marija Kataržytė ir Jūros technologijų ir gamtos mokslų fakulteto vyresnioji mokslo darbuotoja Tatjana Paulauskienė.
Kitas inovatyvus produktas, kuriamas drauge su Universitetu, yra aerogelis. Tai – iš celiuliozės atliekų (popieriaus ir/ar cigarečių filtrų) gaminamas ekonomiškas, efektyvus ir aplinkai draugiškas naftos teršalų sorbentas. Kuriamas produktas, lyginant jį su rinkoje egzistuojančiais analogais, yra mažiausiai dvigubai efektyvesnis, lengvesnis, turi didelį poringumą ir gali būti pakartotinai panaudojamas. Inovatyvių produktų verslo idėjos plėtojamos pasitelkus Klaipėdos mokslo ir technologijų parko, MITA „TechHub“ prie-akceleratoriaus, „InterInoLT“ ir „Inospurtas“ programų inovacijų ir verslumo ekspertus.
Lietuvos švariųjų technologijų klasteris vienija netaršių technologijų srityje veikiančias įmones, mokslo ir studijų institucijas bei kitus subjektus, kooperuojančius savo profesines žinias, įgūdžius, dalykinius ryšius, reputaciją ir patirtį, siekiant bendrų tikslų, susijusių su narių konkurencingumo didinimu bei Lietuvos, kaip švariųjų technologijų valstybės, įvaizdžio stiprinimu.
 |
 |